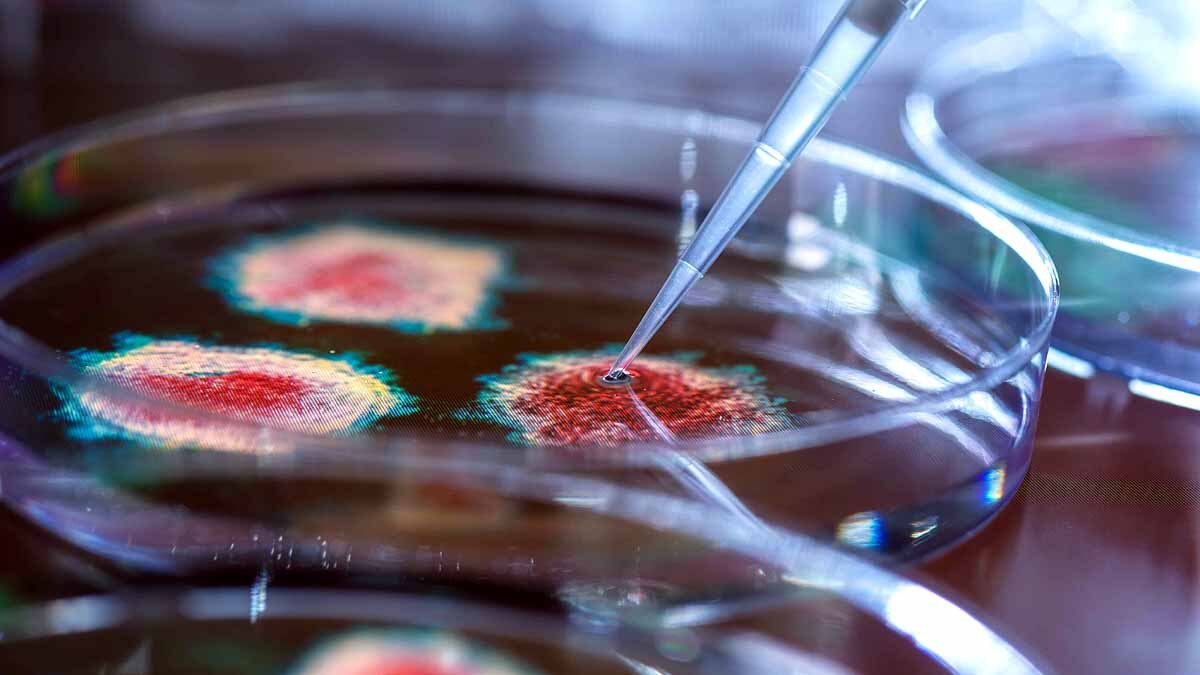
Luck is important for Successful Coronavirus

'सफल कोरोनावायरस' बनने के लिए किस्मत जरूरी, स्टडी में खुलासा
सफल कोरोनावायरस बनने के लिए आपका वायरस होना ही काफी नहीं है. इसके लिए जरूरी है किस्मत. मान लीजिए आप कोरोना वायरस परिवार के नए सदस्य हैं. यानी नए वैरिएंट या स्ट्रेन हैं. आपने अपने अंदर जेनेटिक बदलाव कर लिए. अपने स्पाइक प्रोटीन को भी बदल लिया, ताकि आसानी से इंसान के शरीर की कोशिकाओं को संक्रमित कर सकें. आपके इस बदलाव से हो सकता है कि आपको ऊपर कोरोना की कई इलाज प्रक्रियाओं का असर भी न हो या कम हो. आप इतना कुछ करने के बाद ही प्रतियोगी हो सकते हैं. विजेता नहीं. इसके लिए आपको किस्मत का सहारा लेना पड़ेगा. यानी कोरोना वायरस का हर वैरिएंट तब तक सफल नहीं माना जाता, जब तक उसे किस्मत की मदद नहीं मिलती. (फोटोःगेटी)
कोरोनावायरस की किस्मत का फैसला होता है उसकी एक इंसान के शरीर से निकलकर कई अन्य लोगों को संक्रमित करने की क्षमता पर. अमेरिका के सिएटल स्थित फ्रेड हचिंसन कैंसर रिसर्च सेंटर के साइंटिस्ट्स ने खुलासा किया है कि कोरोनावायरस के कई वैरिएंट्स इस समय दुनिया में मौजूद हैं. लेकिन इस समय कुछ ही हैं जो खुद को स्थापित कर पाए हैं यानी इन नए वैरिएंट्स में से कुछ ही ऐसे हैं जो लोगों को ज्यादा नुकसान पहुंचा रहे हैं. (फोटोःगेटी)
कोरोनावायरस की स्टडी में खुलासा हुआ है कि इतने कोरोनावायरस में से सुपरस्प्रेडर वही वायरस बने जो किस्मत वाले थे. इसके लिए जरूरी है सही वातावरण, लोगों की मौजूदगी, बंद पब्लिक टॉयलेट, खुली राजनीतिक रैली, बंद इनडोर सभा, मास्क न लगाने और सोशल डिस्टेंसिंग न मानने वाले लोग. अगर ये सारी चीजें एकसाथ या इनमें से ज्यादातर स्थितियां मिल जाती हैं तो कोरोनावायरस का नया वैरिएंट संक्रमण फैलाने के लिए सफल माना जाता है. (फोटोःगेटी)
कम से कम नया वैरिएंट 20 लोगों को संक्रमित करे. किसी शख्स या कई लोगों के पूरी तरह बीमार होने के बाद भी निष्क्रिय अवस्था में रहे या दूसरे लोगों को संक्रमित करता चला जाए. ऐसे में होता ये है कि नया वैरिएंट एक महीने के अंदर म्यूटेशन करके नया वायरस स्ट्रेन बना लेता है. इस तरह वो तेजी से कई लोगों को संक्रमित करने लगता है. इसी सफलता को साइंटिस्ट्स किस्मत का नाम दे रहे हैं. (फोटोःगेटी)
इस समय दुनिया में पांच ऐसे कोरोनावायरस वैरिएंट्स हैं जिन्होंने इन सभी बाधाओं को पार करके लोगों को संक्रमित करने में सफलता हासिल की है. इन पांचों वैरिएंट्स ने पूरी दुनिया में सिर्फ छह महीने में ही कहर ढाया है. ऐसा नहीं है कि सिर्फ यही पांच वैरिएंट हैं जो संक्रमण फैलाने में सफल हुए हैं. साइंटिस्ट्स के अनुसार ऐसे कई और वैरिएंट्स हैं जो अपनी किस्मत का इंतजार कर रहे हैं. यानी बाकी वैरिएंट्स को जैसे ही उपयुक्त समय और मौका मिलेगा वो भी खुद को सफल बनाने की पूरी कोशिश में लग जाएंगे. (फोटोःगेटी)
फ्रेड हचिंसन कैंसर रिसर्च सेंटर के साइंटिस्ट्स ने अपनी स्टडी को MedRxiv साइट पर डाला है. इस साइट पर साइंटिस्ट अपनी रिसर्च का रिजल्ट डालते हैं. फिर इस पर पीयर रिव्यू किया जाता है. साइट पर बताया जाता है कि इस स्टडी के परिणाम अभी प्रारंभिक हैं. इसे और बड़े पैमाने पर करने की जरूरत है. (फोटोःगेटी)
Luck is essential for any successful #coronavirus variant, study shows https://t.co/OvgSLB81XA
— Medical Xpress (@medical_xpress) March 27, 2021
साइंटिस्ट्स ने कहा है कि फिलहाल घबराने की जरूरत नहीं है क्योंकि कोविड-19 के वैरिएंट्स लगातार बदल रहे हैं. फिर भी उनका बेसिक बिहेवियर यानी सामान्य तौर-तरीका एक जैसा ही है. यानी संक्रमण फैलाने का तरीका एक जैसा ही है. इसलिए इनका इलाज किया जा सकता है. इस तरह के फिनोमेनोलॉजिकल (Phenomenological) मॉडलिंग स्टडी से महामारी के बीच पनप रहे नए वायरसों के अध्ययन में मदद मिलती है. (फोटोःगेटी)
जैसे ही कोरोनावायरस को लगता है कि उसने एक इंसान के प्रतिरोधक क्षमता यानी इम्यूनिटी को खत्म कर दिया है. या बेहद कमजोर कर दिया है, वह दूसरे लोगों को संक्रमित करने की फिराक में आ जाता है. इस स्टडी को करने वाले साइंटिस्ट डॉ. जोशुआ टी. शिफर ने कहा कि ऐसे मॉडलिंग स्टडी से कोरोनावायरस के नए वैरिएंट्स के बिहेवियर का पता चलता है. इससे पता चलता है कि कौन सा वायरस कितना खतरनाक है. कौन सा लंबा टिकेगा. कौन सा वायरस वैक्सीन को धोखा दे सकता है. (फोटोःगेटी)
डॉ. जोशुआ कहते हैं कि कोरोनावायरस के कई वैरिएंट्स आने की तैयारी में हैं. इनके कोई नाम नहीं हैं अभी तक लेकिन जब ये आएंगे तो बाकी खतरनाक कोरोनावायरसों के स्ट्रेन की तरह ही प्रभावी हो सकते हैं. डॉ. जोशुआ की टीम ने अपनी स्टडी से ये रिजल्ट निकाला है कि ऐसी महामारियों में कई ऐसे वैरिएंट्स लगातार फिराक में रहते हैं कि वो इवॉल्व हों और लोगों को और परेशान करें. क्योंकि वायरस को भी अपना जीवन चक्र पूरा करना होता है. इसके लिए वो पूरा संघर्ष करते हैं. (फोटोःगेटी)
डॉ. जोशुआ कहते हैं कि इस समय कोरोनावायरस के फैमिली ट्री में नए वैरिएंट्स और स्ट्रेन की दर्जनों शाखाएं हैं. हर शाखा के वायरस ने कुछ न कुछ जेनेटिक बदलाव या छेड़खानी की है. कई नए वैरिएंट्स हर दिन पैदा होते हैं लेकिन वो सर्वाइव नहीं कर पाते. जो कर जाते हैं वो लोगों को परेशान करने में कोई कसर नहीं छोड़ते. (फोटोःगेटी)
जैसे ही उच्च स्तर पर संक्रमण के लिए उपयुक्त वातावरण दिखता है ये सारे वैरिएंट्स खुद को सफल साबित करने का प्रयास करने लगते हैं. यानी जब बीमारी के फैलने का सही समय आता है तब कई कमजोर से दिखने वाले कोरोनावायरस वैरिएंट खुद को इवॉल्व करते हैं. वो भयानक रूप में आने लगते हैं. जो वैरिएंट बायोलॉजिकल एडवांटेज के साथ बाहर आता है वो सफलता हासिल कर लेता है. यानी सही जेनेटिक बदलाव, सही तरीके का म्यूटेशन, उपयुक्त वातावरण और इंसानों की लापहवाही. जैसे ही माहौल मिलता है कमजोर कोरोना वैरिएंट भी मजबूत हो जाता है. (फोटोःगेटी)
इसलिए इस स्टडी में बताया गया है कि जैसे ही लगे की कोरोनावायरस के नए वैरिएंट कहर बरपा सकते हैं. उसी समय संक्रमण को बढ़ाने वाले माहौल को कमजोर करना चाहिए. जैसे - सरकार और कई संस्थानों ने निर्देश दिया कि लोग होली, ईद जैसे त्योहारों में सोशल डिस्टेंसिंग और मास्क पहनने के सारे नियमों का कड़ाई से पालन करें. (फोटोःगेटी)